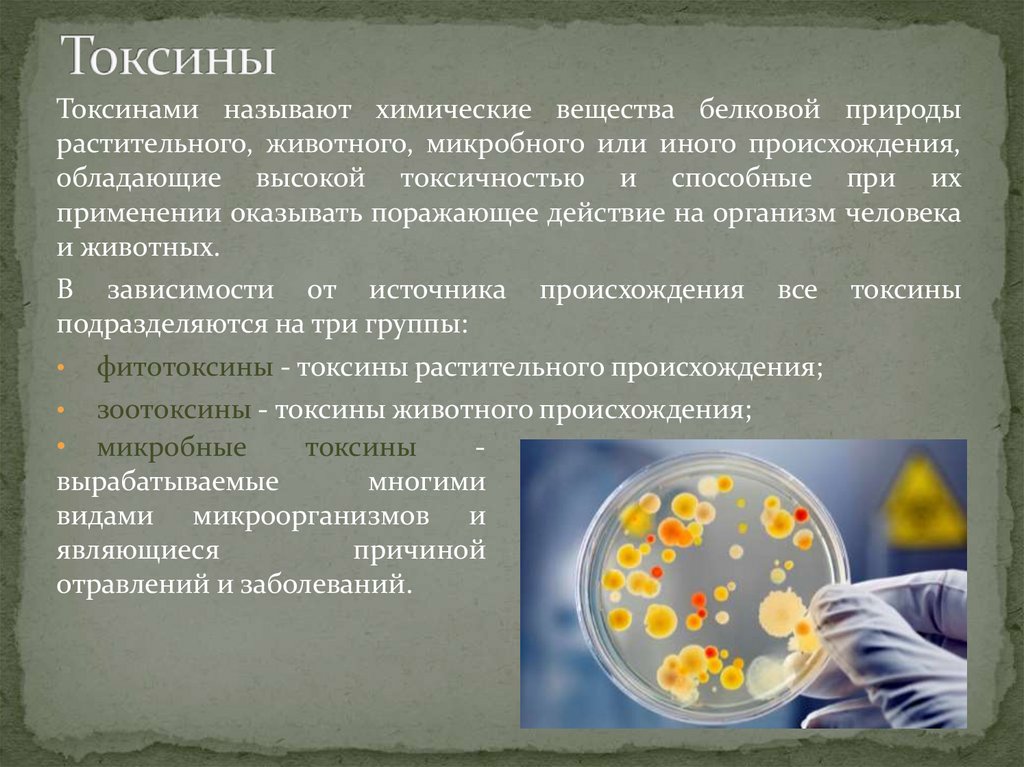
Токсины

Similar presentations:
Тема №16 Ядерное, химическое, биологическое и зажигательное оружие
1. Алтайский Государственный Технический Университет им. И.И. Ползунова
Военная кафедрапри АлтГТУ им.И.И. Ползунова
2. Тема №16
Ядерное, химическое,биологическое и
зажигательное оружие
Время: 1 час
3. Литература
Учебник сержантатанковых войск 2004
г.. с. 194-217;
Подготовка офицеров
запаса, 1989г.. с. 354383.
4. Учебные цели: 1. Ознакомить студентов с основными видами ОМП. 2. Воспитывать ответственность за принимаемые решения
Учебные вопросы2.1 Ядерное оружие.
2.2 Химическое оружие.
2.3 Биологическое оружие.
2.4 Зажигательное оружие
5. Оружие массового поражения
ОМП – это оружие большой поражающейспособности, предназначенное для уничтожения,
разрушения и заражения людей, техники, различных
сооружений и объектов, создание зон заражения,
пожаров и затоплений в значительном масштабах и на
больших площадях.
Поражающее действие ОМП в течение определённого
после его применения может сохраняться и оказывать
сильное морально-психологическое воздействие
6. Существующие виды ОМП
ЯдерноеХимическое
Биологическое
Зажигательное
Последние достижения науки и техники делают возможным создание
ОМП, основанных на качественно новых принципах (инфразвуковое,
радиологическое, лучевое, этническое и др.).
В империалистических странах ведётся интенсивная и организуется
масштабное производство новых разновидностей ОМП (нейтронное
оружие, бинарные химические боеприпасы, лазерное оружие и др.).
7. 2.1 Ядерное оружие
Ядерное оружие.Виды ядерных взрывов.
Характеристика поражающих факторов ядерных
взрывов.
Воздействие поражающих факторов на личный
состав, вооружение, военную технику и другие
объекты.
8.
Ядерным оружиемназывается оружие массового поражения
взрывного действия, основанное на
использовании внутриядерной энергии,
выделяющейся при цепных реакциях
деления тяжелых ядер некоторых
изотопов урана и плутония или при
термоядерных реакциях синтеза легких
ядер изотопов водорода (дейтерия и
трития в более тяжелые), например ядра
изотопов гелия.
9.
Критическая массаp n
n
аβγ
n
p n
p n
n
p n
n
p n
n
p n
n
p n
p n
n
p n
n
n
n
p n
n
n
Цепная ядерная реакция
p n
p n
p
Граница
вещества
n
10.
Ядерный взрыв сопровождается выделением огромногоколичества энергии, поэтому по разрушающему и
поражающему действию он в сотни и тысячи раз может
превосходить взрыв самых крупных боеприпасов,
снаряженных обычными взрывчатыми веществами.
Ядерное оружие включает все виды ядерных боеприпасов
и средства их доставки к цели.
Ядерным боеприпасом называются боевые (головные)
части ракет, авиационных бомб, артиллерийские снаряды,
торпеды и мины, снаряженные ядерным зарядом.
11. Простейшее ядерное устройство
> МкрТоловый заряд
Толовый
заряд
U235 Pl239
< Mкр
12.
Мощность ядерных боеприпасов выражают тротиловымэквивалентом, т. е. таким количеством тротила в тоннах,
при взрыве которого выделяется такое же количество
энергии, что и при взрыве данного ядерного боеприпаса.
В зависимости от мощности ядерные боеприпасы
подразделяются на пять калибров:
сверхмалые ( до 1 тыс. т. )
малые ( от 1 тыс. т. до 10 тыс. т. )
средние ( от 10 тыс. т. до 100 тыс. т. )
крупные ( от 100 тыс. т. до 1 млн. т. )
сверхкрупные ( свыше 1 млн. т. )
13.
В зависимости от характера объекта и задачядерного удара ядерный взрыв может быть
произведен в воздухе, на поверхности земли, под
землей или под водой.
воздушный
В соответствии с
этим различают
взрывы:
высотный
наземный
подземный
подводный
14. Воздушный ядерный взрыв
это взрыв, произведенный на высоте до 10 км, когда светящаясяобласть взрыва не касается поверхности земли (воды). Воздушный
взрыв может быть высоким и низким. При низком воздушном
взрыве подымающейся столб пыли соединяется с облаком взрыва.
При высоком воздушном взрыве столб пыли как правило не
соединяется с облаком. Сильное радиоактивное заражение
местности образуется только вблизи эпицентров низких воздушных
взрывов.
Наиболее
полно
при
воздушном ядерном взрыве
проявляются:
световое излучение
ударная волна
Проникающая радиация
ЭМИ.
15. Высотный ядерный взрыв
это взрыв, произведенный с целью уничтожения в полете ракет исамолетов на безопасном для наземных объектов высоте (свыше 10
км). Поражающими факторами высотного взрыва являются:
ударная волн проникающая радиация световое излучение ЭМИ
Зарево, возникшее в
результате высотного
ядерного взрыва
16. Наземный (надводный ) ядерный взрыв
это взрыв, произведенный на поверхностиземли (воды), при котором светящаяся
область касается поверхности земли
(воды), а пылевой (водяной) столб с
момента образования соединен с облаком
взрыва.
Характерной особенностью наземного
(надводного) ядерного взрыва является
сильное
радиоактивное
заражение
местности (воды) как в районе взрыва, так
и по направлению движения облака взрыва.
Поражающими факторами этого взрыва
являются:
ударная волна
световое излучение
проникающая радиация
радиоактивное заражение местности
электромагнитный импульс
17. Подземный (подводный) ядерный взрыв
это взрыв произведенный под землей (под водой) и характеризующийсявыбросом большого количества грунта (воды), перемешанного с
продуктами ядерного взрывчатого вещества. Поражающее и
разрушающее действие подземного ядерного взрыва определяется в
основном сейсмовзрывными волнами, образованием воронки в грунте и
сильным радиоактивным заражением местности. Световое излучение и
проникающая радиация отсутствует.
Подземные
взрывы
могут
осуществляться для разрушения особо
важных подземных, сооружений и
образования завалов в горах в
условиях, когда допустимо сильное
заражение местности и объектов.
18. Поражающие факторы ядерного взрыва
1• Ударная волна
2
• Световое излучение
3
• Проникающая радиация
4
• Радиоактивное заражение
5
• Электромагнитный импульс (ЭМИ)
19.
Ударная волна представляетсобой область резкого и
сильного сжатия среды,
распространяющейся во все
стороны от центра взрыва со
сверхзвуковой скоростью.
20.
На долю ударной волны приходится 40 - 50 % общейэнергии, освобождающейся при ядерных взрывах.
Расстояние 1 км ударная волна проходит за 2 с, 2 км - за 5
с, 3 км - за 8 с. За это время человек, увидев вспышку,
может укрыться и тем самым уменьшить вероятность
поражения ударной волной или вообще избежать его.
21.
Ударная волна по своей структуре неоднородна: онасостоит из области сжатия и области разряжения.
Передняя граница области сжатия называется фронтом
ударной волны. В зоне сжатия воздух движется
в
направлении от центра взрыва, а в зоне разрежения - в
обратном направлении.
22.
УВ (при Р=1Мт) на своем пути разрушает здания исооружения, образуя четыре зоны разрушений (полных,
сильных, средних, слабых) в зависимости от расстояния :
Зона полных разрушений — до 3км
Зона сильных разрушений — до 5км
Зона средних разрушений — 7-10км
Зона слабых разрушений — более 10км
23.
Ударная волна вызывает различные по степенитяжести поражения:
Легкие поражения — 0,2-0,4кг/см2 (контузии,
легкие ушибы).
Средней тяжести — 0,4-0,6кг/см2 (потеря
сознания, повреждение органов слуха,
вывихи конечностей, кровотечение из носа и
ушей, сотрясение мозга).
Тяжелые поражения — 0,6-1кг/см2 (сильные
контузии, переломы конечностей, поражение
внутренних органов).
Крайне тяжелые поражения — более 1кг/см2 (
со смертельным исходом).
24.
Световое излучениеТ=30000 °С
tдейст.=10-15с
ультрафиолет
видимый свет
инфракрасное излучение
Световое излучение — совокупность видимого света и близких к
нему по спектру ультрафиолетовых и инфракрасных лучей. Источник
светового излучения — светящаяся область взрыва, состоящая из
нагретых до высокой температуры веществ ядерного боеприпаса,
воздуха и грунта . Температура светящейся области > 30000 °С.
Единица светового импульса — джоуль на квадратный метр (Дж/м²)
или калория на квадратный сантиметр (кал/см²). 1 кал/см² = 40 кДж/м².
25.
Поражение людей СИ выражается впоявлении ожогов четырех степеней на
кожном покрове и действием на глаза .
Действие СИ на кожу вызывает ожоги:
1 – степени – краснота, припухлость, отек кожи – 100-200 кДж/м2,
2 – степени – образование пузырей – 200-400 кДж/м2,
3 – степени – образование язв и омертвление кожи – 400-600
кДж/м2
4 – степени – обугливание кожи, омертвление глубоких слоев
кожи и тканей
– более 600 кДж/м2.
Действие СИ на глаза:
временное ослепление – до 30 мин
ожоги роговицы и век
ожог глазного дна – слепота
26. Проникающая радиация
- это поток гамма-лучей инейтронов, испускаемых из зоны ядерного взрыва. Время
действия гамма- лучей до 10 - 15 с, нейтронов - доли
секунды. Распространяясь в воздухе на расстояние до 2-3
км, эти излучения проходят через живую ткань, ионизируя
атомы и молекулы, входящие в состав клеток. В следствии
этого в организме возникают процессы, приводящие к
нарушению жизненных функций отдельных органов и к
развитию лучевой болезни. Тяжесть лучевой болезни
зависит от дозы радиации, полученной человеком.
Единицей дозы излучения является рентген, доза
поглощения радиации измеряется в радах. Соотношение
между рентгеном и радом зависит от материала среды (для
биологической ткани 1Р= 0,93 рад.)
27.
Допустимые дозы облучения людей.Однократная - 50 Р;
Многократная
в течение 10 суток - 100 Р:
в течение 3 месяцев - 200 Р:
в течение года- 300 Р;
Защитой от проникающей радиации служат
различные материалы, ослабляющие гаммаизлучение и поток нейтронов. Из боевой техники
практически
защитными
свойствами
от
проникающей
радиации
обладают
танки
(ослабляют поражающую радиацию в 10 раз),
другие бронированные машины и объекты (БТР в 4
раза).
28. Лучевая болезнь
первой степени (доза радиации в пределах от 100до 250 Р). Сопровождается общей слабостью, повышенной
утомляемостью, головокружением, тошнотой. Продолжительность
заболевания - несколько дней.
Лучевая болезнь второй степени (доза 250 до 400 Р) отмечаются
признаки болезни первой степени, а также головная боль,
повышение температуры и желудочно-кишечные расстройства. В
большинстве случаев лучевая болезнь второй степени
заканчивается выздоровлением пораженных через 1,5-2 месяца.
Лучевая болезнь третьей степени (доза радиации 400 до 700 Р)
является головная боль, повышенная температура, слабость,
резкое снижение аппетита жажда, тошнота, рвота, понос,
изменение в составе крови. Выздоровление может наступить через
несколько месяцев при своевременном и эффективном лечении.
Лучевая болезнь четвертой степени возникает при дозах радиации
выше 700 Р и приводит к смертельному исходу.
29.
ДЕЙСТВИЕ ПРОНИКАЮЩЕЙ РАДИАЦИИбетон
кирпич
грунт
Половинное ослабление проникающей
радиации обеспечивает слой бетона
толщиной 10 см (1), кирпича (2) или
обычного грунта толщиной 14 см (3),
дерева толщиной 30 см (4).
на тело человека (проникает насквозь);
дерево
на различные материалы
30.
При дозах 1000 Р и более развивается молниеносная форма лучевойболезни, при которой личный состав быстро теряет боеспособность
и погибает через несколько дней.
Лучевая болезнь. Последствия
атомного взрыва. Хиросима
31.
Радиоактивное заражение местностизаражение
местности
и
находящихся на ней объектов, а также
воздуха и воды радиоактивными
веществами,
образующимися
при
ядерных
взрывах.
Основные
источники радиоактивного заражения
- радиоактивные продукты (осколки)
деления
ядерного
горючего,
перемешанного с грунтом, водой и др.
материалами.
Это
32.
Область пространства, в котором происходит осаждениерадиоактивных частиц из облака взрыва и верхней части
пылевого столба, называется шлейфом облака. Из
шлейфа наблюдается выпадение радиоактивных частиц.
Вначале из облака выпадают наиболее крупные частицы
с высокой степенью их активности, по мере удаления от
места взрыва - более мелкие, а мощность дозы излучения
при этом постепенно снижается.
33. По степени опасности для личного состава радиоактивный след условно делится на четыре зоны:
зона А- умеренное заражение (уровень радиации на внешней
границе зоны 8 Р/ч);
зона Б - сильное заражение (
уровень радиации на внешней
границе зоны 80 Р/ч);
зона В - опасное заражение (
уровень радиации на внешней
границе зоны 240 Р/ч):
зона Г- чрезвычайно опасное
заражение ( уровень радиации
на внешней границе зоны 300
Р/ч);
След радиоактивного облака наземного ядерного
взрыва с уровнем радиации на 1 ч после взрыва:
1 - направление среднего ветра; 2 - ось следа;
А - зона умеренного заражения; Б - зона сильного
заражения; В - зона опасного заражения;
Г - зона чрезвычайно опасного заражения;
L - длина следа; b - ширина следа
Размеры зон радиоактивного
заражения зависят от мощности и
вида взрыва, а также скорости
ветра
и
могут
достигать
нескольких километров в ширину
и нескольких десятков и даже
сотен километров в длину.
34. Предельно допустимые величины заражения различных объектов
НаименованиеМощность дозы мР/Ч
Поверхность тела человека
20
Обмундирование, снаряжение, обувь,
средства индивидуальной защиты
30
Внутренние поверхности
продовольственных складов» колодцев,
хлебопекарен
50
Техника, техническое имущество
200
Для зашиты личного состава, действующего на зараженной
местности» используют вооружение и военную технику,
естественные укрытия и фортификационные сооружения.
35. Электромагнитный импульс(ЭМИ).
Электромагнитныйимпульс
мощные
электромагнитные поля возникшие в результате
ядерного взрыва, который наиболее полно проявляется
при наземных и низких воздушных ядерных взрывах.
Под действием ЭМИ в радиоэлектронной и
электротехнической
аппаратуре
наводятся
электрические токи и напряжения, которые могут
вызвать
пробои
изоляции,
повреждение
трансформаторов,
порчу
полупроводниковых
элементов, перегорание плавких вставок и других
элементов радиотехнических устройств. Наиболее
подвержены воздействию ЭМИ линии связи,
сигнализации и управления.
36.
UU<15000В
37.
Защита от ЭМИ обеспечиваетсяэкранированием
линий
энергоснабжения,
связи
и
различных
электро
и
радиотехнических устройств.
Наружные линии должны быть
двухпроводными,
изолированными от земли.
Основные варианты
ЭМИ-обстановки:
1. ЭМИ - обстановка района
источника и образования полей
излучения наземного и воздушного
взрывов;
2. Подземная ЭМИ - обстановка на
некотором расстоянии от взрыва
вблизи поверхности;
3. ЭМИ - обстановка высотного
взрыва
38. Комбинированные поражения
Поскольку поражающие факторы ядерного взрывадействуют практически одновременно, то у людей,
находящихся на небольшом расстоянии от центра взрыва,
весьма часто будут наблюдаться комбинированные
поражения, представляющие собой сочетание ранений,
контузий, ожогов и поражений от проникающей
радиации и радиоактивных веществ. Комбинированные
поражения создают значительные трудности при
лечении; травмы и ожоги осложняет течение лучевой
болезни, а радиационные поражения в свою очередь
усложняют лечение ран и ожогов.
39. 2.2 Химическое оружие.
Химическое оружие.Классификация и характеристика отравляющих
веществ.
Средства применения отравляющих веществ,
способы применения химического оружия.
40.
Химическое оружие– это оружие
массового
поражения, действие
которого основано на
токсических
свойствах некоторых
химических веществ.
К нему относятся
боевые
отравляющие
вещества и средства
их применения
41.
Отравляющие вещества(ОВ) –
токсичные химические соединения,
обладающие
определенными
физическими
и
химическими
свойствами,
которые
делают
возможным их боевое применение
в целях поражения живой силы,
заражения местности, вооружения
и военной техники
Основными путями проникновения
ОВ внутрь организма являются
органы дыхания и кожные покровы.
Кроме того, возможно попадание
ОВ в организм человека через
раневые поверхности и через
желудочно-кишечный тракт.
42. Классификация и токсикологические характеристики ОВ
ОВХарактер воздействия на
организм
Признаки поражения
Зарин,
зоман, VX
(V-газы)
нервно-паралитического
действия
смертельные
слюнотечение, сужение зрачков,
затруднение дыхания, тошнота, рвота,
судороги, паралич
Иприт,
азотистый
иприт
кожно-нарывного
(резорбтивного) действия
смертельные
общее отравление организма,
покраснение кожи, образование пузырей,
язвы, повышение температуры
фосген,
дифосген
удушающего действия
смертельные
поражение органов дыхания,
сладковатый неприятный вкус, кашель,
головокружение, слабость
синильная
кислота,
хлорциан
общеядовитого действия
смертельные
металлический привкус, раздражение
горла, головокружение, слабость, рвота,
резкие судороги, паралич
хлорацетофе
нон, адамсит,
CS(Си-Эс)
раздражающего действия
временно выводящие из
строя
острое жжение и боль во рту, горле и в
глазах, сильное слезотечение, кашель,
затруднение дыхания
BZ (Би-Зэт)
психохимического
временно выводящие из
строя
психические расстройства
(галлюцинации, страх, подавленность),
физические расстройства(слепота,
глухота)
43.
Классификация отравляющих веществ1. По тактическому назначению ОВ распределяются по характеру их
поражающего действия (смертельные, временно вывод из строя,
раздражающие, учебные)
2. По физиологическому действию на организм человека (нервно паралитического, общеядовитого, удушающего, кожно-нарывного,
психохимического, раздражающего)
3. По быстроте наступления поражающего действия
(быстродействующие и медленнодействующие)
4. В зависимости от продолжительности сохранения поражающих
способности ОВ смертельного действия подразделяются на две
группы (стойкие до нескольких суток и нестойкие до нескольких
часов)
44.
Боевое состояние ОБ - такое состояние вещества, в котором оноприменяется на поле боя с целью достигнуть максимального
эффекта в поражении живой силы.
Различают следующие боевые состояния отравляющих веществ:
парообразное (ОВ находится в атмосфере в виде пара или газа);
аэрозольное (жидкие и твердые ОВ взвешены в воздухе в виде,
частиц различного размера);
капли - крупные частицы, которые в отличии от аэрозолей
оседают на поверхность быстро.
аэрозольное
состояние
Парообразное
состояние
45. Бинарные системы химического оружия
Термин «бинарный» означает «состоящий из двух частей».Конструкция «бинарного» боеприпаса включает два контейнера,
каждый из которых заполнен нетоксичным или малотоксичным
компонентом снаряжения.
Бинарный артиллерийский снаряд: 1-Головной взрыватель; 2- Корпус снаряда;
3 и6 – Контейнеры с хим. Компонентами; 4 – свободное пространство;
5 – разрывные диски; 7 – Донная крышка.
Компонент снаряжения представляет собой индивидуальное
соединение или химическую смесь, подобранные таким образом,
чтобы при смешении содержимого обоих контейнеров в боеприпасе в
короткое время образовалось высокотоксичное вещество.
46. Токсины
Токсинами называют химические вещества белковой природырастительного, животного, микробного или иного происхождения,
обладающие высокой токсичностью и способные при их
применении оказывать поражающее действие на организм человека
и животных.
В зависимости от источника происхождения все токсины
подразделяются на три группы:
• фитотоксины - токсины растительного происхождения;
• зоотоксины - токсины животного происхождения;
• микробные
токсины
вырабатываемые
многими
видами микроорганизмов и
являющиеся
причиной
отравлений и заболеваний.
47.
Газовая бомбовая кассетастроение химической
авиационной бомбы
48. Химические боевые части ракет
служат для поражения живой силыпутем заражения воздуха парами ОВ.
Головная часть ракеты MGR-1
49. Химические фугасы, шашки, гранаты и патроны
являютсясредствами ближнего боя.
химические фугасы - служит для заражения местности каплями и
аэрозолями ОВ;
химические шашки, гранаты и патроны - служат для поражения
живой силы раздражающими и временно выводящими из строя
ОВ в виде аэрозоля.
Химический фугас
образца 1937 года с
запальным шнуром.
50.
Химическая шашка и граната:а - химическая шашка М16;
б – Химическая граната М7А2
Химические
гранаты
Химические фугасы М1 и АВС-М23
51. Химические боевые приборы
- средства поражения многократногоиспользования. К ним относятся выливные авиационные приборы и
механические генераторы аэрозолей ОВ.
Выливные авиационные приборы (ВАП) - служат для поражения живой
силы путем заражения воздуха, местности, боевой техники и
вооружения ОВ. По конструкции ВАП - металлический резервуар
обтекаемой формы различной вместимости.
Выливной авиационный
прибор TMU - 28B
Выливной авиационный
прибор ВАП-6.
52.
Механические генераторы аэрозолей ОВ - служат для поражениянезащищенной живой силы путем заражения воздуха порошками и
аэрозолем растворов раздражающих ОВ. В состав механического
генератора входят: резервуар, источник давления, распыляющее
приспособление.
Мощный аэрозольный
генератор (МАГ).
53. 2.3 Биологическое оружие
Биологическое оружиеВиды и основные свойства биологических средств.
Способы и средства применения биологического
оружия.
54.
Биологическое оружие - это специальные боеприпасы и боевыеприборы со средствами доставки, снаряженные бактериальными
(биологическими) средствами.
Поражающее действие бактериального (биологического) оружия
основано в первую очередь на использовании болезнетворных
свойств микробов и токсичных продуктов их жизнедеятельности.
Основу поражающего действия биологического оружия составляют
биологические средства (ЕС) - специально отобранные для
боевого применения биологические агенты, способные вызвать у
людей, животных, растений массовые тяжелые заболевания
(поражения).
Бактериальные
(биологические)
использованы для:
поражения людей
поражения животных
уничтожения растений
средства
могут
быть
55.
способы распространения БС:авиационные бомбы и генераторы аэрозолей;
артиллерийские снаряды и мины;
ракеты ближнего и дальнего действия;
другие беспилотные средства нападения, снаряженные жидкими или
сухими бактериальными рецептурами;
различные наземные специально оборудованные транспортные
машины и приборы для заражения членистоногими;
авиационные бомбы, контейнеры, снаряженные зараженными
членистоногими;
различные приборы и специальная аппаратура для диверсионного
заражения воды, воздуха закрытых помещений, продуктов питания, а
также для распространения зараженных членистоногих и грызунов
56. биологические средства для поражения людей
возбудителибактериальных
заболеваний
(чума,
туляремия,
бруцеллез,
сибирская язва,
холера)
возбудители
риккетсиозов
(сыпной тиф,
пятнистая
лихорадка
Скалистых гор,
Ку-лихорадка)
возбудители
вирусных
заболеваний
(натуральная
оспа, желтая
лихорадка,
венесуэльский
энцифаломиелит
лошадей)
возбудители
грибковых
заболеваний
(кокцидиодомик
оз, покардиоз,
гистоплазмоз)
57. проявления основных болезней
Чума – о.и.з;общая слабость,
озноб,
головная боль,
быстрое
повышение Т°С,
затемнение
сознания;
боль в груди и
кашель;
потеря сознания
и смерть
Сибирская язва о.и.з;
формы
заболевания:
кожная(пузырьки,
язвы, массивный
отек),
легочная,
кишечная
Холера о.и.з.,
понос,
рвота,
судороги,
снижениеT°
до 35 °С
Ботулизм - тяжелое
заболевание;
поражение центральной
нервной системы,
блуждающего нерва,
нервного аппарата
сердца; общая
слабость;
головная боль;
расстройство зрения
(туман перед глазами,
двоение); давление в
подложечной области;
паралитические явления
мышц языка, мягкого
нёба, гортани, лица;
T°С ниже нормальной
58. биологические средства для поражения животных
возбудителиящура
возбудители
сибирской
язвы
возбудители
чумы
крупного
рогатого
скота, чумы
свиней
ложного
бешенства
возбудители
сапа,
африканской
лихорадки
свиней
59. биологические средства для уничтожения растений
возбудителиржавчины
хлебных
злаков
возбудители
позднего
увядания
кукурузы
возбудители
фитофтороза
картофеля
фитотоксиканты,
дефолианты,
гербициды и
другие
химические
вещества
насекомые —
вредители
сельскохозяйствен
ных растений
60.
Бактерии - одноклеточные микроорганизмы, являются возбудителямичумы, холеры, сибирской язвы. Способны через каждые 20 - 30 мин
размножаться простым делением клеток.
Вирусы - группа микроорганизмов, способных существовать в живых
клетках. В сотни и тысячи раз меньше бактерий, являются
возбудителями натуральной оспы, желтой лихорадки.
Риккетсии
- микроорганизмы, занимающие промежуточное
положение между вирусами и бактериями. Живут только в тканях
поражаемых ими органов. Вызывают такие заболевания, как сыпной
тиф, пятнистая лихорадка распространителями которых являются
клещи, вши, блохи.
Грибки
многоклеточные
микроорганизмы
растительного
происхождения. Обладают высокой устойчивостью к высушиванию,
воздействию солнечных лучей и дезинфицирующих средств.
Вызывают такие заболевания, как бластомикоз, гистоплазмоз.
Микробные токсины продукты жизнедеятельности некоторых
видов бактерий, обладающие в отношении человека, животных крайне
высокой токсичностью. Попав с пищей, водой в организм человека,
животных, эти продукты вызывают очень тяжелые, часто со
смертельным исходом поражения.
61.
основные средства защиты отбиологического оружия :
вакцинно-сывороточные
препараты;
антибиотики;
сульфамидные и другие
лекарственные вещества,
используемые для специальной
и экстренной профилактики
инфекционных болезней;
средства индивидуальной и
коллективной защиты,
используемые для
обезвреживания возбудителей
химические вещества
62. 2.4 Зажигательное оружие
• Зажигательное оружие.• Зажигательные вещества и средства
их применения.
63.
Под зажигательным оружием понимают зажигательные вещества (ЗВ) исредства их боевого применения. Оно предназначается для поражения
личного состава уничтожения и повреждения вооружения и военной
техники, сооружений и других объектов.
Зажигательные вещества армий капиталистических государств
подразделяются на три основные группы:
зажигательные составы на основе нефтепродуктов
металлизированные зажигательные смеси
термиты и термитные составы
Особую группу зажигательных веществ представляют:
обычный пластифицированный фосфор.
щелочные металлы, самовоспламеняющаяся на воздухе смесь на
основе триэтилленалюминия.
Зажигательные вещества на основе нефтепродуктов подразделяются:
незагущенные (жидкие);
загущенные (вязкие);
64.
Напалмы обладают способностью легко воспламеняться и развиватьтемпературу до 1200 С. Продолжительность горения напалмов
составляет 5-10 мин. Они хороши прилипают к поверхностям
различных объектов, горят при доступе кислорода, и трудно поддаются
тушению.
Наиболее эффективной огнесмесью считается напалм Б. Он
характеризуется хорошей воспламеняемостью и повышенной
прилипаемостью даже к влажным поверхностям, способен создавать
высокотемпературный (1000-1200 С) очаг с длительностью горения 5-10
мин. Напалм Б легче воды, поэтому плавает на ее поверхности, сохраняя
при этом способность гореть, что значительно затрудняет ликвидацию
очагов пожаров.
65.
Пирогели получают путем добавления в напалмы в виде порошка илистружки натрия, магния, фосфора, а также алюминия, угля, асфальта,
селитры и других веществ. Температура горения достигает 1600 С. В
отличие от обычных напалмов пирогели тяжелее воды, горение их
происходит всего лишь 1-3 мин.
Термитные составы представляют собой порошкообразную спрессованную смесь обычно алюминия и окислов железа. Горящий термит
разогревается до 3000 Си горит без доступа кислорода.
Из термитных зажигательных смесей на вооружении армии США
состоят составы марок ТН2, ТНЗ и ТН4. Они
могут
прожигать
металлические
части
вооружения
и
военной
техники и выводить их из
строя. Указанные термитные
составы
используются
в
авиационных зажигательных
бомбах.
Следы прожега от
термитной смеси.
66.
Белый фосфор представляет собой полупрозрачное твердое вещество,похожее на воск. Он способен самовоспламеняться, соединяясь с
кислородом воздуха. Горит ярким пламенем с обильным выделением
белого дыма. Температура воспламенения порошкообразного фосфора
34 С, температура пламени 900-1200 С. Белый фосфор применяется как
воспламенитель напалма и пирогеля в зажигательных боеприпасах.
Белый фосфор: ужасные последствия применения
67.
Пластифицированныйфосфор
(с
добавками
каучука)
приобретает
способность
прилипать
к
вертикальным
поверхностям и прожигать их. Это позволяет применять его для
снаряжения бомб, мин, снарядов.
Электрон — сплав магния (96%). алюминия (3%) и других
элементов (1%). Воспламеняется при температуре 600 С ,
и горит ослепительно белым или
голубоватым
пламенем,
развивая
температуру до 2800 С. Применяется
для
изготовления
корпусов
авиационных зажигательных бомб.
Самовоспламеняющаяся зажигательная
смесь состоит из полиизобутилена и
триэтиленалюминия
(жидкое
горючее).
68. К средствам боевого применения зажигательных веществ относятся:
• авиационные напалмовые и зажигательные бомбы,зажигательные кассеты и кассетные установки;
• артиллерийские зажигательные боеприпасы;
• огнеметы, реактивные зажигательные гранатометы;
• пристрелочно-зажигательные и бронебойнозажигательные пули;
• винтовочные зажигательные гранаты;
• термитные шашки, шары и пакеты;
• зажигательно-дымовые патроны;
• огневые (зажигательные) фугасы.
69.
зажигательные бомбы и бакиСверху вниз: авиационная напалмовая
бомба; однофунтовая зажигательная
бомба; американский 500-фунтовый
напалмовый бак; кассета с
зажигательными бомбами
зажигательная бомба
70.
огнемет РОКС-11. Резервуар. 2.Снаряжение для переноски. 3.Трубка.
4.Вентиль баллона. 5.Редуктор. 6.Баллон для сжатого
воздуха. 7.Обратный клапан. 8. Успокоитель. 9.Ствол.
10.Ружье-брандспойт. 11. Клапан. 12.Пружина.13.Приклад.
14.Курок. 15.Ползун. 16.Клапанная коробка. 17.Пружина.
18.Ударник. 19. Гибкий рукав
71.
Пули:1 - Б-30 бронебойная;
2 - Б-32 бронебойно-зажигательная;
3 - БТ бронебойно-трассирующая;
4 - БЗТ бронебойно-зажигательнотрассирующая;
5 - БЗТ модернизированная (ЗБ-46);
6 - ЗП (ПЗ) пристрелочнозажигательная.
винтовочная мортирка для метания
зажигательных бутылок.
72.
Зажигательно-дымовой патрон состоитиз пусковой трубки (I), двигателя (2),
генератора (3), крышки (4) и шнура с
кольцом (5).
73. Ручная фосфорная зажигательно-дымовая граната № 77 (Великобритания)
74. Заключение
Вывод: Вследствие больших потерь к которым можетпривести применение противником ОМП защита от
его поражающих факторов является важным
условием
сохранения
боеспособности
войск,
организуется и осуществляется в любых условиях
обстановки. Знание личным составом способов
зашиты от поражающих факторов ОМП - залог
успешного выполнения поставленных задач.

warfare
warfare








